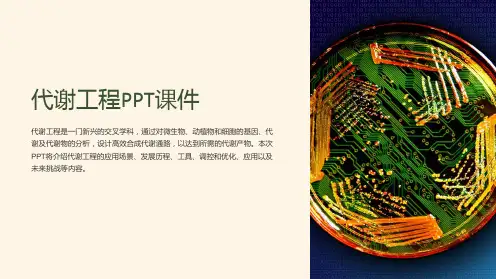

簇类分析(Hierarchical Cluster Analysis ,HCA) 簇类的独立软模式分类法(Soft In- dependent Modeling of Class Analogy, SIMCA)、PLS-DA (PLSDiscriminant Analysis) 、人工神经网络 (Artificial Neural Network,ANN) 等
4
2 代谢组学的概念
在新陈代谢的动态进程中,系统地研究代 谢产物的变化规律,揭示机体生命活动代 谢本质的科学。
5
Metabonomics ---英 Jeremy K.Nicholson 20世纪
90年代
生命体系对病理生理刺激或遗传改造所产生的 动态,多指标代谢响应的定量测定.
Metabolomics ---Oliver Fiehn需要,可将 组织行甲醇除蛋白、庚烷除脂肪及冻干等处 理),加至质谱仪,经历汽化,离子化、加速分离 及检测分析后即可得出相应代谢产物或是代谢 组的图谱。图谱中每个峰值对应着相应的分子 量,结合进一步的检测分析可以部分鉴定出化 学成分以及半定量关系。
34
(3)常用的其他一些分析技术
代谢产物的检测、分析与鉴定是代谢组学 技术的核心部分,最常用的方法是有两种
NMR 质谱(MS)
28
(1)核磁共振技术
原理
核磁共振技术核磁共振是原子核的磁矩在恒定 磁场和高频磁场同时作用,且满足一定条件时 所发生的共振吸收现,是一种利用原子核在磁 场中的能量变化来获得关于核信息的技术. 生 命科学领域中常用的有三种
气相色谱(GC) 高效液相色谱仪(HPLC) 高效毛细管电泳(HPCE)
往往与NMR或MS技术联用,进一步增加其灵敏性。 敏感性及分辨率提高,“假阳性”率也就越大
![[课件]代谢组学PPT](https://uimg.taocdn.com/e3e3b24cb84ae45c3a358c12.webp)

![中学课件植物细胞的结构与代谢产物[可修改版ppt]](https://uimg.taocdn.com/047bb2e402d276a200292eab.webp)


